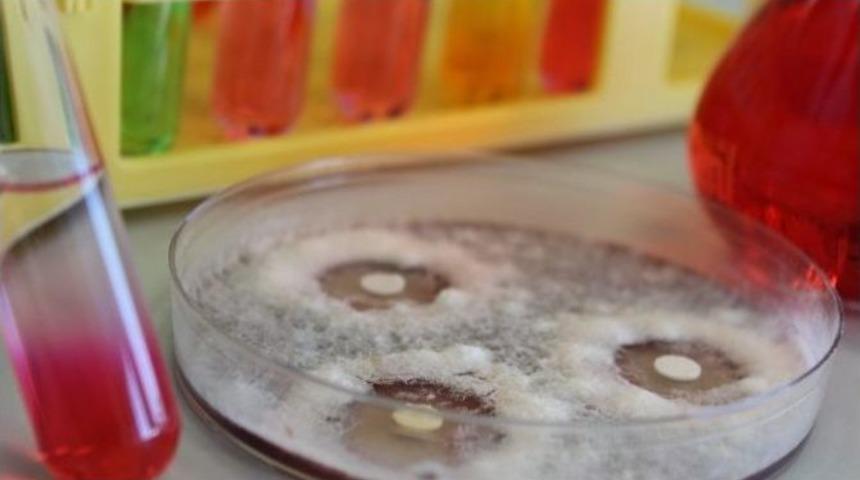
Niğde &Uuml;niversitesi İnsana Ve Doğaya Zarar Vermeyen Tarım İlacı &Uuml;retti

Niğde Üniversitesinde Nanobiyoteknolojik yöntemlerle meyve ve sebzelerin yapısında bulunan biyoaktif moleküller kullanılarak insan sağlığına ve doğaya zarar vermeyen tarım ilaçları geliştirildi.Niğde Üniversitesi, Hacettepe Üniversitesi ile yürüttüğü ortak çalışma sonucunda meyve ve sebzelerde bulunan ve yüksek antimikrobiyal etkiye sahip bazı moleküllerden, çevreye zarar vermeyen tarım ilaçları geliştirdi.“Niğde Üniversitesi Ayhan Şahenk Tarım Bilimleri ve Teknolojileri Fakültesi” öğretim üyelerinden Prof. Dr. Mustafa Özgen ve çalışma grubu ile Hacettepe Üniversitesi Nanoteknoloji ve Nanotıp Anabilim Dalı öğretim üyeleri tarafından yürütülen proje kapsamında geliştirilen tarım ilaçlarının uzun süre etkili, yüksek verimli, çevre dostu ve sürdürülebilir olduklarının tespit edildiği belirtildi.Özellikle son yıllarda tarım ürünlerinde karşılaşılan ilaç kalıntılarının insan sağlığına ve çevreye olumsuz etkilerini yok etmek üzere daha etkin çözüm arayışı içinde bulunulurken yürütülen bu proje ile nano boyutta üretilen ilaçların gelecekteki zirai mücadele çalışmaları için umut vaat ettiği ifade edildi.Tarımda kullanılan ilaç ve gübrenin çevreye zararını azaltmada en yeni teknolojilerden birisinin “Nanoteknoloji” olduğunu vurgulayan Niğde Üniversitesi Ayhan Şahenk Tarım Bilimleri ve Teknolojileri Fakültesi Öğretim Üyesi Prof. Dr. Mustafa Özgen, konuyla ilgili olarak şunları söyledi;“Nanoteknoloji, tarım alanında; bitki hastalıklarını önlemede, erken hastalık tespitinde, zirai ilaç ve gübre kullanımını azaltmada, bitki ve hayvan ıslahı çalışmalarında kullanılmaya başlanmıştır. Nanoteknolojinin biyoloji ayağı olan nanobiyoteknoloji uygulamaları ile tarım sektöründe daha az maliyet ile daha yüksek verim ve kaliteye ulaşmak, insan ve çevre sağlığına duyarlı sürdürülebilir tarımı gerçekleştirmek mümkün olacaktır. Tarım ilaçlarının toksik olmayan kimyasallardan faydalanılarak yapılması çevreci ve sürdürülebilir bir tarım için hedeflenmektedir. Bitki kökenli bazı moleküllerin yüksek oranda pestisit özelliğine sahip olduğu yapılan çalışmalar kapsamında ön plana çıkarılmıştır. Sayıları yaklaşık 40 binin üzerinde olan biyoaktif moleküller daha çok kırmızı meyve ve sebzeler, turunçgiller, soğan, baklagiller ve çayda bol miktarda bulunmaktadır. Toksik etkisi bulunmayan ve doğal antimikrobiyal ajan özelliğindeki bu biyoaktif moleküllerden doğal tarım ilaçlarının geliştirilmesi gelecekteki çevre dostu pestisit çalışmaları için örnek olacaktır.”Prof. Dr. Mustafa Özgen elde edilen sonuçların insan ve çevre sağlığına dost, sürdürülebilir bir tarım için ümit verici bir başlangıç olduğunu belirterek laboratuvar çalışmalarında elde edilen başarılı sonuçların uygulamaya aktarılması çalışmalarının sürdürüldüğünü söyledi. 


Anadolu Ajansı ve İHA tarafından yayınlanan yurt haberleri Mynet.com editörlerinin hiçbir müdahalesi olmadan, sözkonusu ajansların yayınladığı şekliyle mynet sayfalarında yer almaktadır. Yazım hatası, hatalı bilgi ve örtülü reklam yer alan haberlerin hukuki muhatabı, haberi servis eden ajanslardır. Haberle ilgili şikayetleriniz için bize ulaşabilirsiniz